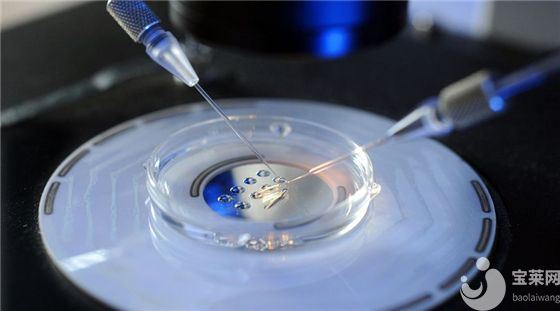
試管嬰兒之第一代技術

試管嬰兒在現實生活中已經算是很普遍的事情,所以當人們提起時都不會覺得很奇怪,也更不會帶有色眼睛去看待。隨著不孕不育的人群增加,更多的不孕家庭都選擇試管嬰兒來孕育自己的寶寶,但是做試管嬰兒也要特別注意年齡的,特別是女性,試管嬰兒對女性的年齡要求非常高,過了育齡年齡做試管嬰兒成功率會低于年輕女性。
臨近幾年,各項生育醫學技術不斷成熟,而且用于培養細胞的細胞培養液比之前更加好,醫務人員的技術經驗也更豐富,在全世界范圍內試管嬰兒的成功率大大的提高了。

現在越來越多的女性被婦科疾病所困擾,一開始因為只是小病小痛所以就容易被忽略,而等它逐漸發展成為婦科疾病時,再去治療就會相對比較困難。

隨著做試管嬰兒的人群不斷增加,有大部人一次就能成功,而有少部分的人不管試了多少次都很難成功,那么,為什么別人一次就能成功,而你試了這么多次還是沒能成功呢?

大部分不孕患者在做完試管移植后,最關注的就是在飲食上面了,因為大多數患者會擔心不小心吃錯東西,萬一失敗了那前面的努力就白費了,那么為了提

大多數不孕家庭想利用試管嬰兒的治療孕育寶寶,但是,也有大部分女性在猶豫,因為怕做試管嬰兒取卵后會對自己的卵巢有影響,那到底是不是正跟大家所想的一樣,做完試管嬰兒取卵后卵巢有不適?

大多數不孕夫妻在做試管嬰兒之前,都很關注取卵后對卵巢是否過度的傷害,還能不能恢復到最初的模樣等問題,其實,這個不用太過于擔心,了解清楚后,就會知道取卵對卵巢不會造成任何傷害。

相信大家對試管嬰兒已經不再陌生,而且也已經逐漸接受了試管嬰兒寶寶,試管嬰兒經過幾十年的發展,技術上面確實是改善了不少,但是它的成功率還是沒有達到百分百,大多數患者做試管嬰兒的時候還是會面臨著失敗的可能,所以還是會有大部分患者會擔心失敗了還能不能再做。

對于一個家庭來說,家里如果是兒女雙全的情況,那這樣可以算是人生贏家了。但是由于現在生活壓力比較大,導致大多數人在懷孕這件事上沒有辦法正常受孕,但是又特別想孕育一個自己的孩子,所以會采用試管嬰兒的方法,而取卵正是整個環節最重要的部分,但是過多的卵子致使卵巢有一定的損傷,那么取卵后如何恢復卵巢?

李先生和張女士在婚姻的愛河中已經走過15年,雖然生活富足,婚姻幸福,但始終沒有自己的孩子,這對于處在中年時期的夫妻來說,是殘酷的。李先生說他和妻子算是晚婚的,太太比他小6歲,身體一切都很正常,但是他自己去醫院檢查,醫生說他是弱精癥者,李先生始終對太太張女士有愧疚之情,但是太太每次都給李先生安慰,說總會有辦法的。為了要孩子,曾經李先生夫婦在國內做過2次試管嬰兒,但是結果都以失敗告終,唯一慶幸的就是當時張女士還在美國進行了卵子冷凍,當時冷凍了15顆卵子,到現在已經有5年了。